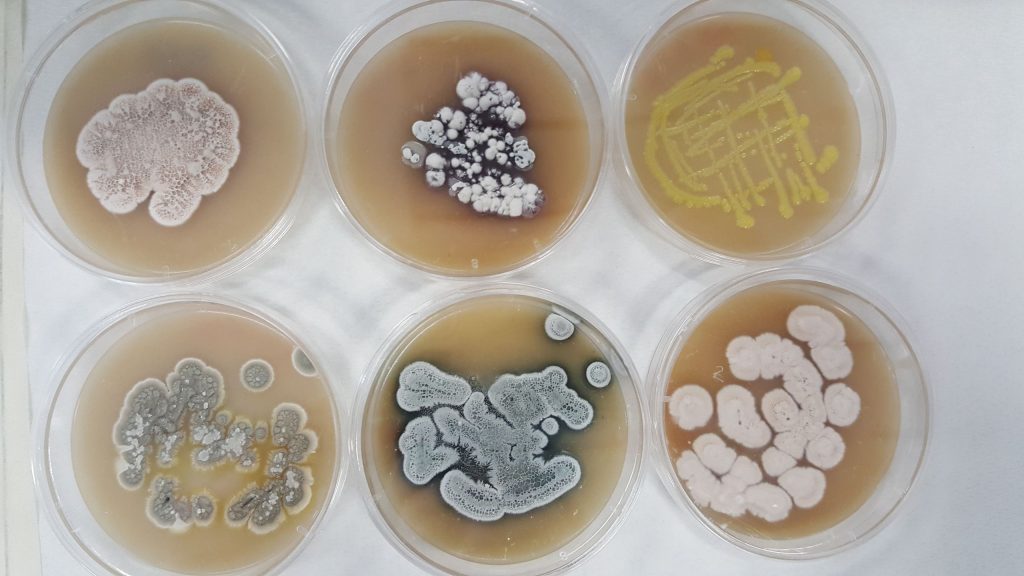
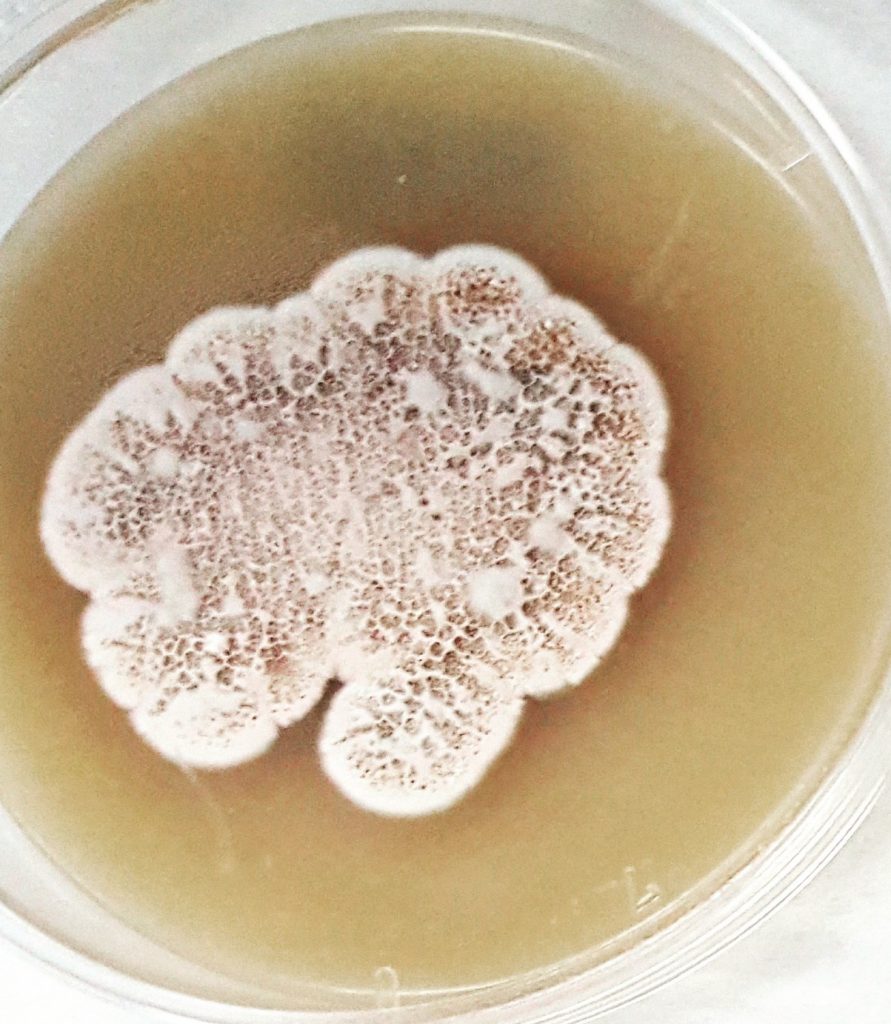

FERMENTATION PLATFORM: from plates to bioreactors
In our Lab we have a STRAIN COLLECTION with more then 600 microbial strains, and 3 thermostaed INFORS shaker for flask-level fermentation trials

We could SCALE-UP fermentation processes in our 3 L and 5 L Applikon Bioreactors for secondary metabolites and heterologous proteins production



DOWNSTREAM PLATFORM
Antibiotic, natural products and heterologous proteins could be analysed and recovered by our Ge Helthcare FPLC system and our 2 VWR HPLC equipped with Diode Array and Refractive Index detectors


